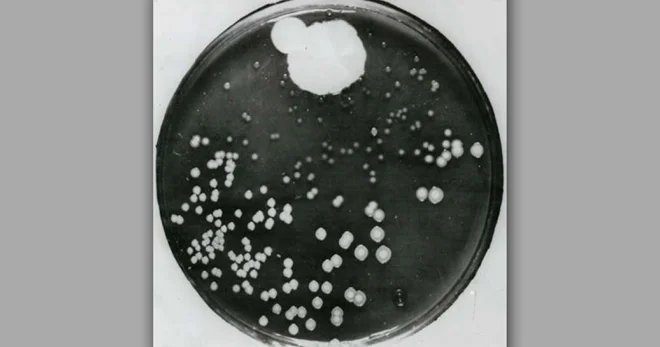
La fameuse boîte de Petri de Fleming avec la zone claire autour de la moisissure

Un laboratoire en désordre, un chercheur négligent, et une moisissure qui change le cours de l'histoire médicale. Les plus grandes découvertes arrivent toujours quand on s'y attend le moins – un peu comme ce patient belge qui, juste avant un toucher rectal, m'avait lancé : "Attends avant de me le mettre bien profond le français, on va négocier." L'histoire de Fleming, c'est exactement ça : une négociation inattendue avec le hasard.

Fleming observant sa découverte fortuite dans son laboratoire
L'accident qui sauva des millions de vies
Alexander Fleming n'était pas ce qu'on appellerait un scientifique méticuleux. Ses collègues du St. Mary's Hospital de Londres se moquaient régulièrement du chaos qui régnait dans son laboratoire. Des boîtes de Petri empilées n'importe comment, des cultures oubliées pendant des semaines, des paillasses encombrées... Si vous aviez visité son labo en 1928, vous auriez probablement pensé qu'il était temps pour Fleming de changer de métier. Moi qui ai passé mon PhD aux Pays-Bas (où l'ordre règne en maître, au point qu'ils appellent "bagage" quelque chose qui se prononce "barrage" – j'ai mis trois mois à comprendre pourquoi on m'annonçait constamment des inondations à l'aéroport), je peux vous dire que Fleming n'aurait jamais survécu une semaine à Leiden.
Heureusement pour nous tous, cette négligence apparente allait mener à l'une des découvertes les plus importantes de l'histoire de la médecine.
Nous sommes en septembre 1928. Fleming, 47 ans, travaille sur les staphylocoques – ces bactéries sournoises responsables d'infections parfois mortelles. Avant de partir en vacances (oui, même les futurs Nobel prennent des congés), il empile négligemment ses boîtes de culture dans l'évier, sans même prendre la peine de les nettoyer. "Je m'en occuperai au retour", se dit-il probablement.
À son retour, plusieurs semaines plus tard, Fleming s'apprête à jeter toutes ces cultures "ratées" quand il remarque quelque chose d'étrange sur l'une d'elles. Une moisissure verte s'est développée, et autour d'elle... plus rien. Les bactéries ont tout simplement disparu.
Un autre chercheur aurait sans doute haussé les épaules et jeté la boîte à la poubelle. Moi, par exemple. Je l'avoue : si j'avais trouvé de la moisissure dans mes cultures, ma première réaction aurait été de tout désinfecter et de prétendre que rien ne s'était passé (un peu comme quand j'explique à mes patients que "non, non, c'est tout à fait normal que je consulte Google pendant l'examen"). Mais Fleming, malgré son côté brouillon, possédait ce que tous les grands scientifiques partagent : une curiosité insatiable et un œil pour l'inattendu.
La fameuse boîte de Petri de Fleming avec la zone claire autour de la moisissure
De l'observation à la révolution
Fleming venait de découvrir la pénicilline, mais il ne le savait pas encore. Il savait seulement qu'une moisissure du genre Penicillium (d'où le nom qui viendra plus tard) produisait une substance capable de tuer les bactéries. C'était fascinant, certes, mais Fleming était biologiste, pas chimiste.
Et c'est là que l'histoire devient presque tragique. Fleming essaie bien d'isoler et de purifier cette mystérieuse substance, mais sans succès. Il publie ses observations dans quelques articles scientifiques que pratiquement personne ne lit. La pénicilline retombe dans l'oubli pendant plus de dix ans.
Imaginez : pendant que Fleming luttait avec ses éprouvettes, des millions de personnes continuaient à mourir d'infections banales. Un père de famille emporté par une pneumonie, une mère décédée après l'accouchement, des soldats victimes de leurs blessures infectées... Tous auraient pu être sauvés si la pénicilline avait été disponible. Combien de Fleming potentiels rangent en ce moment même leurs découvertes dans un tiroir en se disant "bah, ça ne marche pas" ?
Le duo qui a changé l'histoire
Il a fallu attendre 1940 et l'arrivée d'Howard Florey (un Australien déterminé) et Ernst Boris Chain (un biochimiste allemand réfugié) à Oxford pour que la pénicilline révèle enfin son potentiel. Ces deux hommes, aidés par une équipe internationale, ont réussi là où Fleming avait échoué : purifier et produire la pénicilline en quantités utilisables.
Le premier patient à recevoir de la pénicilline purifiée fut l'agent de police Albert Alexander, le 12 février 1941. Hospitalisé pour une infection grave après s'être égratigné l'œil avec une épine de rose (oui, vraiment), il était condamné. La pénicilline fit des miracles : en quelques jours, l'infection régresse spectaculairement.
Malheureusement, les stocks s'épuisèrent et Alexander rechuta mortellement. Mais le principe était prouvé : la pénicilline pouvait sauver des vies.
L'âge d'or des antibiotiques
La Seconde Guerre mondiale allait transformer cette découverte de laboratoire en révolution médicale. Les États-Unis, comprenant l'enjeu stratégique, investirent massivement dans la production industrielle de pénicilline. En 1943, les soldats alliés bénéficiaient de ce "médicament miracle" qui transformait des blessures autrefois mortelles en blessures guérissables.

Des soldats sauvés par la pénicilline : le "médicament miracle" change le cours de la guerre
Fleming, Florey et Chain reçurent conjointement le prix Nobel de médecine en 1945. Mais leur découverte ouvrait surtout la voie à l'âge d'or des antibiotiques. En moins de vingt ans, les chercheurs enchaînèrent les trouvailles : la streptomycine contre la tuberculose, la tétracycline, l'érythromycine... Une molécule après l'autre, comme si la nature avait gardé ses meilleurs secrets pour les livrer tous en même temps.
Ces molécules révolutionnèrent littéralement la médecine. La tuberculose, fléau millénaire, devint curable. La mortalité infantile chuta drastiquement. Les chirurgies complexes devinrent possibles sans risque majeur d'infection. En quelques décennies, l'humanité semblait avoir vaincu les maladies infectieuses.
Nous étions si confiants que certains experts prédisaient la fin pure et simple des infections bactériennes. "Dans vingt ans, on n'aura plus besoin d'hôpitaux pour les maladies infectieuses", affirmaient certains optimistes. Ils se trompaient lourdement – un peu comme moi quand je pense que manger une deuxième boule de glace n'aura aucun impact sur ma ligne...
Le retour de bâton : l'émergence des superbactéries
Fleming lui-même avait vu venir le problème. Dès 1945, dans son discours de réception du Nobel, il lançait un avertissement prophétique : "Il n'est pas difficile de rendre les micro-organismes résistants à la pénicilline en laboratoire en les exposant à des concentrations insuffisantes pour les tuer."
Cette prédiction se réalisa plus vite qu'attendu. Dès 1947, soit seulement quatre ans après l'introduction clinique de la pénicilline, les premières résistances apparurent. Les bactéries, dans leur lutte millénaire pour la survie, avaient développé des stratégies pour contrer ces nouvelles armes.
Comment les bactéries résistent-elles ?
Les mécanismes de résistance sont d'une sophistication étonnante — une guerre où l'ennemi apprend en temps réel à déjouer vos stratégies. Certaines bactéries fabriquent des "ciseaux moléculaires" qui découpent l'antibiotique avant qu'il n'agisse. D'autres changent la serrure que l'antibiotique essaie d'ouvrir. Les plus malignes installent carrément des pompes d'évacuation qui rejettent l'antibiotique dès qu'il entre dans la cellule. Et le pire : elles peuvent s'échanger ces recettes de résistance entre elles, même d'espèces différentes — comme des criminels qui partageraient leurs techniques d'évasion par télépathie.

Les différents mécanismes de résistance bactérienne : comment les bactéries déjouent nos antibiotiques
Les superbactéries d'aujourd'hui
Aujourd'hui, nous faisons face à des bactéries résistantes à presque tous nos antibiotiques. Aux États-Unis, environ 35 000 personnes meurent chaque année d'infections résistantes aux antibiotiques, contre 13 000 décès liés au VIH - un renversement dramatique de la situation. Les entérobactéries productrices de carbapénémases (EPC) résistent même à nos antibiotiques de "dernier recours". L'OMS parle d'une "ère post-antibiotique" où des infections banales pourraient redevenir mortelles.
Ce que vous devez savoir aujourd'hui
Face à cette menace grandissante, que peut faire chacun d'entre nous ? Pas grand chose de spectaculaire, en réalité. Finir son traitement même quand on se sent mieux. Ne pas réclamer des antibiotiques pour un rhume viral. Ne pas se soigner avec les restes de la boîte du voisin. Des choses que tout le monde sait et que personne ne fait.
La recherche ne s'avoue pas vaincue pour autant. Les scientifiques explorent des pistes fascinantes : des virus qui infectent spécifiquement les bactéries (les bactériophages), des peptides antimicrobiens inspirés de défenses naturelles, des nanoparticules qui délivrent les antibiotiques directement dans les bactéries...
L'intelligence artificielle au secours des antibiotiques
Une révolution silencieuse est en marche dans les laboratoires du monde entier. L'intelligence artificielle accélère désormais la découverte de nouveaux antibiotiques. Là où il fallait autrefois des décennies pour identifier une molécule prometteuse, les algorithmes peuvent maintenant cribler des millions de composés en quelques heures.
En 2020, des chercheurs du MIT ont utilisé l'IA pour découvrir l'halicine, un antibiotique capable de tuer certaines superbactéries. Le nom rend hommage à HAL 9000, l'ordinateur de "2001 : L'Odyssée de l'espace" – un clin d'œil qui aurait sûrement amusé Fleming.
Le microbiote : l'écosystème invisible qui change tout
Pendant que nous nous battions contre les "mauvaises" bactéries, nous avons découvert que des milliards de "bonnes" bactéries vivent en harmonie avec nous. Notre microbiote intestinal – cette communauté de micro-organismes qui peuple nos intestins – s'avère être un acteur majeur de notre santé.
Les dernières recherches révèlent des liens fascinants : la composition de notre microbiote pourrait influencer l'efficacité des immunothérapies contre le cancer. Certaines bactéries intestinales semblent "booster" notre système immunitaire, rendant les traitements anti-cancer plus efficaces. D'autres, au contraire, pourraient les freiner.
Une révolution en cours
Des équipes testent des "cocktails" de bonnes bactéries pour améliorer les traitements contre le cancer. Imaginez : votre flore intestinale comme co-pilote dans la lutte contre les tumeurs. Fleming n'aurait jamais imaginé que ses ennemis bactériens deviendraient un jour nos alliés les plus précieux.
Cette découverte nous rappelle encore une fois l'humilité nécessaire en médecine. Nous avons passé des décennies à essayer d'éliminer les bactéries, pour découvrir que certaines sont indispensables à notre survie. La leçon de Fleming continue : parfois, la solution se trouve exactement là où on ne l'attend pas.
Le paradoxe moderne
Nous vivons un paradoxe fascinant. D'un côté, nous développons des thérapies révolutionnaires : immunothérapies contre le cancer, thérapies géniques, médecine personnalisée. De l'autre, nous risquons de perdre notre capacité à soigner une simple infection urinaire.
C'est comme si nous avions appris à aller sur Mars mais que nous avions oublié comment réparer une roue crevée.
La leçon de Fleming
L'histoire de Fleming nous enseigne que les plus grandes découvertes naissent parfois du hasard et de l'observation attentive. Mais elle nous rappelle aussi une vérité fondamentale : chaque victoire médicale appelle à l'humilité.
Les bactéries nous précèdent sur Terre de quelques milliards d'années. Elles ont survécu aux météorites, aux glaciations, aux éruptions volcaniques. Elles ont appris à s'adapter, à évoluer, à résister. Penser que nous pourrions les vaincre définitivement avec quelques molécules était peut-être un peu présomptueux.
Aujourd'hui, alors que nous développons des thérapies géniques révolutionnaires et des immunothérapies sophistiquées, les leçons de l'histoire des antibiotiques restent cruciales. Chaque nouvelle arme thérapeutique doit être utilisée avec sagesse, en gardant à l'esprit que notre adversaire – qu'il s'agisse de bactéries, de virus ou de cellules cancéreuses – évolue et s'adapte constamment.
Et maintenant ?
L'odyssée qui a commencé par une moisissure dans un laboratoire londonien continue. De nouveaux Fleming travaillent en ce moment même dans des laboratoires du monde entier, peut-être sur la prochaine révolution médicale. Certains étudient le microbiome intestinal, d'autres développent des antibiotiques "intelligents" qui ne s'activent qu'en présence de certaines bactéries.
La course entre l'humanité et les micro-organismes n'aura probablement jamais de fin. Et c'est peut-être mieux ainsi. Cette pression constante nous oblige à innover, à rester vigilants, à ne jamais tenir nos victoires pour acquises.
Fleming l'avait prédit dès 1945, cette course n'aurait pas de vainqueur définitif. Mais grâce à des chercheurs curieux, des médecins attentifs, et des patients informés, nous gardons une longueur d'avance.
Pour l'instant.
La prochaine fois que vous prenez un antibiotique...
Pensez à Fleming et à sa moisissure fortuite. Pensez aux millions de vies sauvées grâce à cette découverte. Et rappelez-vous que ce petit comprimé que vous tenez dans votre main représente près d'un siècle de recherche, d'innovation et de lutte contre l'invisible. Utilisez-le à bon escient.
